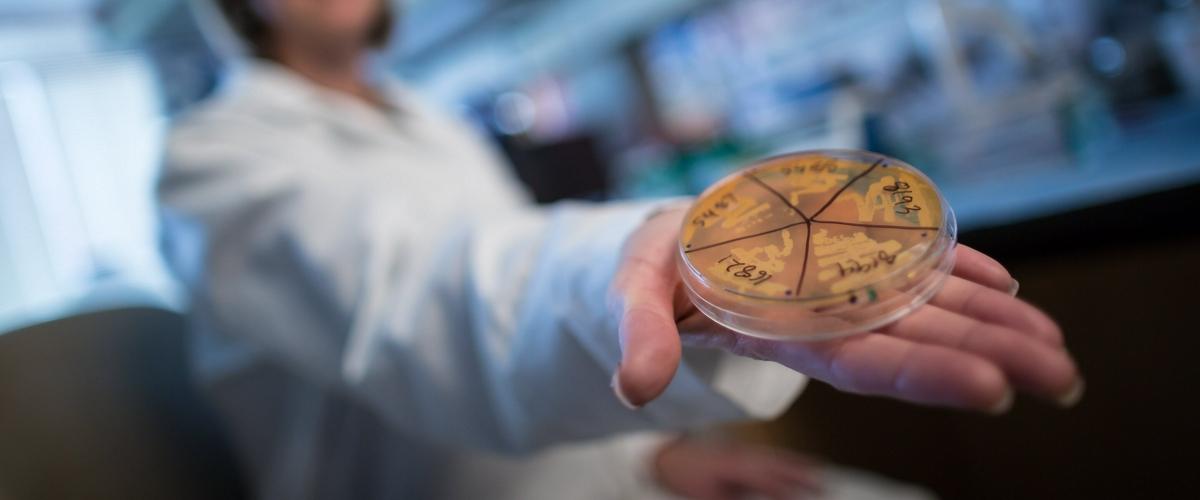
TODO:

В последние годы накапливается все больше свидетельств о влиянии симбиотических бактерий кишечника на здоровье всего организма. Согласно новейшему исследованию специалистов из Университета штата Юта, определенный класс бактерий предотваращает ожирение у грызунов — и, возможно, у человека.
Как сообщает Medical Xpress, на первом этапе работы члены команды обратили внимание, что генетически модифицированные мыши с искусственно ослабленным иммунитетом страдают от ожирения намного чаще нормальных сородичей. Как показал дальнейший анализ, неправильная работа иммунной системы приводила к нарушению баланса между различными видами кишечных бактерий.
Выяснилось, что внутренняя среда стала неблагоприятной для бактерий из класса Clostridia, которые блокируют поглощение жира. Без них кишечник абсорбировал намного больше жира, что привело к чрезмерному увеличению веса даже при сбалансированном питании.
У некоторых грызунов даже развились признаки диабета второго типа. При этом если эти бактерии искусственно возвращали в кишечник, грызуны оставались стройными.
Затем исследователи сравнили две группы мышей. У первой микробиом был уничтожен полностью, а у второй сохранились только клостридии. Представители второй группы отличались меньшим количеством жировых запасов, а гены, связанные с поглощением жирных кислот, работали у них менее активно.

Возможно, сходные механизмы характерны и для человека. По крайней мере, в предыдущих исследованиях у некоторых людей с чрезмерным весом наблюдался дефицит бактерий из группы Clostridia. Кроме того, есть данные, что ожирение и диабет 2 типа связаны с ослабленным иммунным ответом.
Ученые надеются, что открытие поможет по-новому взглянуть на профилактику и лечение проблем метаболизма. В частности, они планируют выделить и изучить терапевтические свойства молекул, с помощью которых клостридии управляют всасыванием жиров. Препараты, основанные на этих соединениях, могли бы стать эффективной и более безопасной альтернативой фекальных трансплантатов и пробиотиков.
Еще одна возможная функция кишечных бактерий — защита мозга от вирусов. Согласно недавнему исследованию, здоровый микробиом помогает иммунной системе бороться с вирусами, способными вызвать нейродегенерацию.